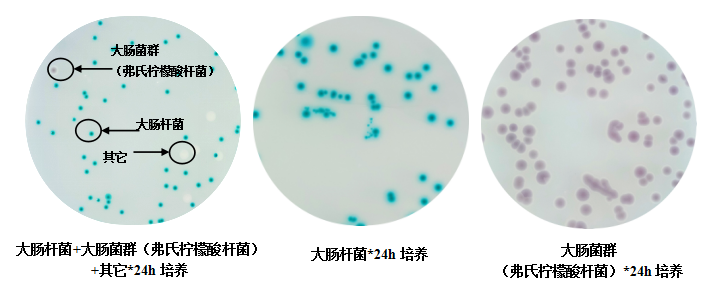
大肠菌群大肠杆菌显色培养基(ECC)

相关产品推荐更多 >
万千商家帮你免费找货
0 人在求购买到急需产品
- 详细信息
- 技术资料
- 库存:
99999
- 英文名:
Chromogenic Coliform & E.coli Agar
- 保质期:
有效期两年
- 供应商:
环凯微生物
- 保存条件:
2-8℃
- 规格:
1000ml/瓶
【产品名称】
【货号、规格、产品形态及包装形式】
货号 规格 产品形态 包装形式
CRM003 32.8g 脱水干粉 瓶装
【产品用途】
用于大肠菌群和大肠杆菌快速检测和计数。
【检验原理】
蛋白胨和酵母膏粉提供氮源和微量元素,氯化钠可维持均衡的渗透压,十二烷基liu suan钠抑制革兰氏阳性菌,琼脂是培养基凝固剂;混合色素分别与大肠菌群和大肠杆菌所对应的酶发生特异性反应,水解底物,释放出显色基团,使大肠菌群产生紫红色的菌落,大肠杆菌产生蓝绿色的菌落;大肠杆菌分解蛋白胨中的色氨酸,生成靛基质,与靛基质试剂作用,在大肠杆菌菌落周围形成玫瑰吲哚而呈红色。
【配方成分】
成分 含量(每升)
蛋白胨 10.0g
琼脂 12.0g
酵母膏粉 3.0g
十二烷基liu suan 钠 0.1g
氯化钠 5.0g
混合色素 2.7g
蒸馏水 1000ml
终末 pH 7.0±0.2
【使用方法】
脱水干粉培养基使用: 称取本品干粉32.8g,用1000mL蒸馏水或纯水溶解。混合均匀加热至100℃,并不断搅拌直至完全溶解,无需灭菌,冷至50℃左右,备用。(注:配制不同用量体积,可按比例扩增或缩小。)后续操作可参考“平板凝胶培养基使用”。
后续操作可参考“平板凝胶培养基使用”。
【质量控制】
1. 外观方面:
平板凝胶/瓶装凝胶培养基:淡黄色凝胶。
下列质控菌株接种待测试培养基,36℃±1℃培养24h,结果如下:

【储存条件及保质期】
平板凝胶/瓶装凝胶:2~8℃,避光保存,有效期三个月。
1、称量脱水干粉培养基时避免粉尘扬起,应佩戴口罩操作以免吸入粉尘引起呼吸道系统不适。
3、质检报告下载:首先,登录环凯网站http://www.huankai.com;然后,打开“客服中心”页面,点击“产品质检报告”,输入产品批号搜索即可。
【废物处理】
Q/HKSJ 03 普通微生物培养基







风险提示:丁香通仅作为第三方平台,为商家信息发布提供平台空间。用户咨询产品时请注意保护个人信息及财产安全,合理判断,谨慎选购商品,商家和用户对交易行为负责。对于医疗器械类产品,请先查证核实企业经营资质和医疗器械产品注册证情况。
技术资料暂无技术资料 索取技术资料









